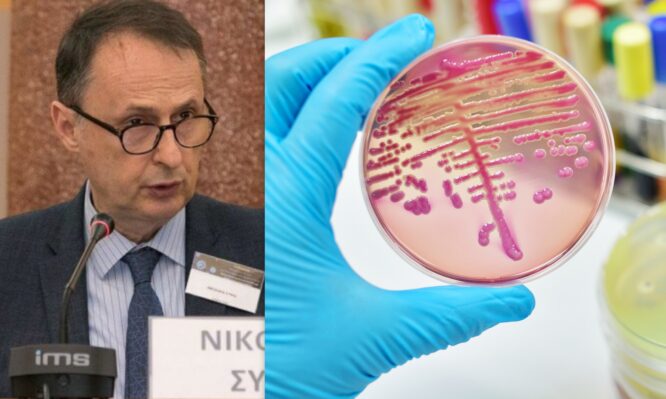

Γιάννα Σουλάκη - IATROPEDIA
Μη ασφαλής υγειονομικά έχει χαρακτηριστεί η Ελλάδα από το Ευρωπαϊκό Κέντρο Ελέγχου Λοιμώξεων (ECDC), εξαιτίας της μικροβιακής αντοχής.
Τα αντιβιοτικά μας τελείωσαν, ενώ παραμένουν αποκαρδιωτικά τα στοιχεία για τις ενδονοσοκομειακές λοιμώξεις στη χώρα μας. Παρά τα μέτρα που έχουν ληφθεί στην κατεύθυνση της αντιμετώπισης αυτού του σοβαρού προβλήματος, η μικροβιακή αντοχή στοιχίζει χιλιάδες θανάτους στις Μονάδες Εντατικής Θεραπείας (ΜΕΘ).
Σύμφωνα με επίσημα στοιχεία από τον ΕΟΔΥ από το 2000 έως το 2018 η αντίσταση των παθογόνων στα αντιβιοτικά στην Ελλάδα αυξήθηκε κατά 46%, ενώ μόνο το 2020 είχαμε σχεδόν 41.000 λοιμώξεις από πολυανθεκτικά μικρόβια, καταγράφοντας αύξηση 76% σε σύγκριση με το 2016.
Οι έλληνες γιατροί σηκώνουν τα χέρια ψηλά και δηλώνουν πώς δεν έχουν πλέον ισχυρά «όπλα» στη φαρέτρα τους για να πολεμήσουν πανίσχυρα μικρόβια και βακτήρια που ενδημούν στα ελληνικά νοσοκομεία, όπως είναι το ασινετομπάκτερ, η κλεμπσιέλλα και οι ψευδομονάδες.
Αποτελεσματικά -άλλοτε- αντιβιοτικά, όπως, οι καρβαπενέμες, οι τρίτης γενιάς κεφαλοσπορίνες και οι φθοριοκινολόνες παρουσιάζουν σήμερα ισχνή αντίσταση απέναντι στα πανίσχυρα μικρόβια.
«Στον πόλεμο αυτό τα μικρόβια αποδεικνύονται πολύ ισχυρότερα από τον άνθρωπο», τόνισε ο Καθηγητής Παθολογίας Λοιμωξιολογίας στην Ιατρική Σχολή του ΕΚΠΑ, Νικόλαος Σύψας, επισημαίνοντας πως το προβλημα παραμένει, παρά τη θεσμοθέτηση του ελέγχου της χρήσης των αντιβιοτικών με την ηλεκτρονική συνταγογράφηση.
Δεν απέκλεισε μάλιστα, ως ένα επιπλέον μέτρο ελέγχου της χρήσης, να θεσμοθετηθεί υποχρεωτικό αντιβιόγραμμα στα νοσοκομεια πριν από τη χορήγηση αντιβιοτικου.
Καθηγητής Σύψας: Το τέλος των αντιβιοτικών και οι επιπτώσεις στην Ελλάδα
Στην ομιλία του σε επιστημονική και ενημερωτική συνάντηση με τίτλο, «Η αντιμετώπιση της μικροβιακής αντοχής και η αξία των νεότερων αντιβιοτικών», ο Καθηγητής επισήμανε πως το πρόβλημα είναι μεν πανευρωπαϊκό και παγκόσμιο, όμως, η Ελλάδα παραμένει στη δυσμενέστερη και πιο ευάλωτη θέση στην Ευρώπη στον επιπολασμό ενδονοσοκομειακών λοιμώξεων.

Σύμφωνα με επίσημα στοιχεία του 2023 στα νοσοκομειακά παθογόνα η χώρα μας είναι αρνητική «πρωταθλήτρια», με διπλάσιες από τον μέσο όρο της ΕΕ Λοιμώξεις Σχετιζόμενες με τη Φροντίδα Υγείας (ΛΣΦΥ).

Σε δραματικούς τόνους ο Καθηγητής και πρόεδρος της Ελληνικής Εταιρείας Λοιμώξεων, κ. Σύψας, επισήμανε πώς τα αντιβιοτικά, που αποτελούν φάρμακα-κλειδί της σύγχρονης ιατρικής, χάνουν τη δύναμή τους απέναντι σε βακτήρια που προσαρμόζονται και εξελίσσονται.
«Πρέπει να συνειδητοποιήσουμε ότι τα αντιβιοτικά τελειώσανε. Επί της ουσίας, δεν υπάρχει κανένα νέο αντιβιοτικό. Και γιατί δεν υπάρχει κανένα νέο αντιβιοτικό; Γιατί καταστρέψαμε αυτά που είχαμε και γιατί καμία φαρμακευτική εταιρεία δεν επενδύει, γιατί είναι πάρα πολύ μεγάλο το κόστος για να βγουν νέα αντιβιοτικά», τόνισε ο επιστήμονας.
Η Ελλάδα στο μικροσκόπιο της Ευρώπης
Η εικόνα που παρουσίασε ο καθηγητής Νίκος Σύψας είναι «σκοτεινή»: Η Ελλάδα είναι 1η στην Ευρωπαϊκή Ένωση σε κατανάλωση αντιβιοτικών στην κοινότητα και 6η στην ενδονοσοκομειακή κατανάλωση.
Μικρόβια όπως τα Klebsiella pneumoniae, Acinetobacter baumannii και Pseudomonas aeruginosa εμφανίζουν αντοχή σε πολλαπλές κλάσεις αντιβιοτικών στα ελληνικά νοσοκομεία, περιορίζοντας δραματικά τις θεραπευτικές επιλογές.
Η κατάσταση αυτή οδήγησε το ECDC να πραγματοποιήσει αυτοψία με ειδικούς επιστήμονες στα ελληνικά νοσοκομεία πριν από ακριβώς ένα χρόνο και στη συνέχεια να εκδώσει οδηγία το 2024 προς τις υπόλοιπες χώρες της Ευρώπης. Η έκθεση χαρακτήρισε την Ελλάδα «unsafe place for patients» («μη ασφαλές μέρος για ασθενείς») και ταυτόχρονα συνέστησε την προληπτική απομόνωση ασθενών που επιστρέφουν από νοσηλεία στην Ελλάδα, εξαιτίας του κινδύνου μετάδοσης πολυανθεκτικών παθογόνων.

Σύμφωνα με τον Καθηγητή Συψα, πέρα από τον βαρύ φόρο αίματος και την υψηλότερη θνησιμότητα, οι λοιμώξεις από ανθεκτικά βακτήρια οδηγούν σε παρατεταμένες νοσηλείες, αυξημένο κόστος φροντίδας και βαρύτερες επιπλοκές .
Σε πολλές περιπτώσεις, μάλιστα, οι γιατροί αναγκάζονται να επιστρέφουν σε παλαιά, τοξικά ή λιγότερο αποτελεσματικά φάρμακα.
Το αδιέξοδο με τα νέα αντιβιοτικά
Σε αυτό το δυσμενές περιβάλλον, η ανάγκη για καινοτόμα αντιβιοτικά είναι επιτακτική. Ωστόσο, το διεθνές σύστημα παραγωγής καινοτομίας σε αυτόν τον τομέα έχει καταρρεύσει. Κι ο λόγος είναι απλός: δεν υπάρχει οικονομικό κίνητρο, όπως τόνισε ο Καθηγητής.
Η ανάπτυξη ενός νέου αντιβιοτικού αγγίζει το αστρονομικο ποσό των 1,5 δισ. δολαρίων και, λόγω των ορθών περιορισμών στη χρήση (για την αποτροπή περαιτέρω αντοχής), τα έσοδα είναι ελάχιστα. Πολλές εταιρείες που ανέπτυξαν επιτυχημένα νέα αντιβιοτικά, στη συνέχεια χρεοκόπησαν.
Τα νέα αντιβιοτικά, σύμφωνα με τον Βασίλη Γραμμέλη, Medical Lead της Pfizer, καταφέρνουν να μειώσουν τη θνητότητα από το 35% στο 5%, κάτι που σημαίνει πώς με τη χρήση τους θα μπορουσαμε να αποφύγουμε, 3 στους 10 θανάτους ασθενών.
Ωστόσο, όπως είπε, «από τη δεκαετία του ’80 και μετά δεν έχει βγει νέα κατηγορία αντιβιοτικών, που να βασίζεται δηλαδή σε κάποιο νέο τρόπο δράσης έναντι των μικροβίων. Αυτό έχει ως αποτέλεσμα να μικρόβια να κάνουν διασταυρούμενη ανοσία και να ισχυροποιούνται έναντι των υπαρχόντων αντιβιοτικών», ανέφερε ο κ. Γραμμέλης.
Το πρόβλημα είναι πολύπλευρο, σύμφωνα με τον Καθηγητή Σύψα: Από τη μία δεν παράγονται νέα φάρμακα, ή νέα καινοτόμα αντιβιοτικά δεν έχουν πάρει τιμή για να κυκλοφορήσουν στη χώρα μας και εισάγονται με το «σταγονόμετρο» μέσω ΙΦΕΤ και ΕΟΦ, ενώ από την άλλη, φθηνά και πολύτιμα για τους ασθενείς αντιβιοτικά δεν τα παράγουν οι εταιρείες λόγω έλλειψης οικονομικού κινήτρου.
«Η κυβέρνηση απαιτείται να εκπονήσει ένα σοβαρό στρατηγικό σχέδιο, για την ανάπτυξη και εισαγωγή αντιβιοτικών ώστε να ισχυροποιηθεί η προσπάθεια μας της χώρας μας στον τομέα αυτό», δήλωσε ο πρόεδρος της ΕΕΛ, κ. Σύψας.

Η ανάγκη για κίνητρα
Στην Ευρώπη μετράμε ετησίως 35.000 θανάτους, αριθμός συγκρίσιμος με εκείνον της γρίπης, της φυματίωσης και του HIV/AIDS μαζί. Την ίδια στιγμή, το ετήσιο κόστος υγειονομικής περίθαλψης και οι απώλειες παραγωγικότητας λόγω της μικροβιακής αντοχής να εκτιμώνται σε 1,5 δισεκατομμύρια ευρώ, ενώ το αντίστοιχο κόστος της μικροβιακής αντοχής στην Ελλάδα (EHR – Ετήσιο Κόστος Υγείας) είναι πάνω από 42 εκατομμύρια ευρώ.
Σύμφωνα με τον Αντώνη Φουστέρη, Director Policy & Public Affairs της Pfizer, το πρόβλημα έχει τόσο μεγάλες διαστάσεις που η μονη λύση φαινεται να είναι η παροχή κινήτρων, ώστε να γίνει περισσότερο βιώσιμη αυτή η κατάσταση.
Έτσι, η διεθνής επιστημονική κοινότητα, όπως επισήμανε, προτείνει πλέον ως λύση τα λεγόμενα pull incentives: οικονομικά μοντέλα, δηλαδή, που αποζημιώνουν την ανάπτυξη ενός νέου αντιβιοτικού ανεξάρτητα από τις πωλήσεις του (π.χ. μέσω συνδρομητικών μοντέλων).
Προκειται ουσιαστικά, για μηχανισμούς αποζημίωσης που ανταμείβουν τις φαρμακευτικές εταιρείες για την επιτυχή ανάπτυξη νέων αντιβιοτικών, ανεξαρτήτως του όγκου πωλήσεων.
Πετυχημένα παραδείγματα αποτελούν η Σουηδία και το Ηνωμένο Βασίλειο, χώρες που έχουν ήδη υιοθετήσει πιλοτικά τέτοια μοντέλα, με θετικά αποτελέσματα.
Μια ακόμη προτεινόμενη λύση, σύμφωνα με τον κ. Φουστέρη, η οποία συζητείται στο πλαίσιο της αναθεώρησης της φαρμακευτικής νομοθεσίας στην ΕΕ είναι και η θέσπιση voucher.
«Το voucher είναι ουσιαστικά ένα κίνητρο για μια εταιρεία που θα ανακαλύψει ένα αντιβιοτικό, να μπορεί -είτε για το αντιβιοτικό αυτό είτε, για ένα άλλο φάρμακό της- να αυξήσει την πατέντα του κατά ένα χρονικό διάστημα. Η πρόταση της Ευρωπαϊκής Επιτροπής είναι κατά 12 μήνες. Αυτό θεωρείται ένα καλό κίνητρο για τις εταιρείες για να μπορέσουν να κάνουν έργο», κατέληξε ο ίδιος.
Αν δεν ληφθούν έγκαιρα μέτρα, όπως τόνισαν σε δραματικους τόνους οι επιστήμονες, προβλέπεται το 2050 να συμβαινουν παγκοσμίως 10 εκατομμύρια θάνατοι ετησίως και να υπάρχει οικονομικό κόστος 100 τρισεκατομμυρίων δολαρίων.
Δεν υπάρχουν σχόλια:
Δημοσίευση σχολίου